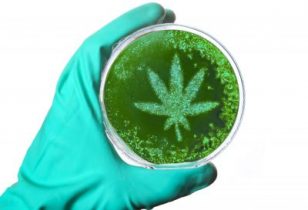

TopStories
- Buitenwiet test ’24 eindigt met een geweldig Oogstfeest!
- Gefeliciteerd Trump – 15 procent van jouw Amerikanen rookt wiet!
- Zijn kunstmatige wietzaden de toekomst? Hoe worden ze gemaakt?
- Nieuw-Zeelandse ‘Doede de Jong’ Brian Borland al 10x veroordeeld voor wiet
- Fasciation vs. polyploïden, en het voordeel van triploïde wietplanten
- Buitenwiet test ’24 update #28: laatste update van het jaar!
Schimmels en vervuiling in wietolie en zalf voorkomen
Steeds meer mensen maken hun eigen medicijn op basis van cannabis. Maar om ervoor te zorgen dat iemand niet zieker wordt van dat product, is het van belang om vervuiling door micro-organismen zoals schimmels te vermijden. Door onder meer hygiënisch en steriel te werken en het product op de juiste manier te bewaren voorkom je dit en verzeker je jezelf van een schoon product.
Schimmels in cannabis
We leven in een wereld vol met micro-organismen, dit zijn kleine ‘levende wezentjes” die je niet met het blote oog kunt zien. Virussen, schimmels en bacteriën zijn voorbeelden van micro-organismen. Als we het over microbiologie hebben dan bedoelen we daarmee biologie op microscopisch niveau.
Micro-organismen zijn nuttig, ze sluiten kringlopen en helpen ons bij de afvalverwerking. Ze zijn in dienst bij ons – in fabrieken maken ze bier, wasmiddelenzymen en insuline. Sommige schimmels maken een belangrijk onderdeel uit van de levenscyclus van het plantenrijk. Maar ze zijn ook een vijand, ze veroorzaken ziekte en bederf.
Wanneer je dus een zalf maakt is het verstandig om voldoende ‘natuurlijke’ conserveringsstoffen toe te voegen
In 2016 is door het RIVM onderzoek gedaan naar vervuiling in cannabis. Hierbij lag de nadruk vooral op bestrijdingsmiddelen en giftige schimmels (aflatoxines). In het onderzoek hebben de onderzoekers 25 samples bekeken en in 23 van deze samples zijn bestrijdingsmiddelen gevonden. In 11 samples was deze concentratie hoger dan is toegestaan volgens de kruidengeneesmiddelenrichtlijn.
Micro-organismen in extracten en cannabisolie
Veel mensen denken dat schimmels en micro-organismen tijdens het extractieproces door de alcohol dood zullen gaan. Ze zijn van mening dat ze dan een schoon product hebben, want de alcohol zou immers alle micro-organismen hebben gedood. In de praktijk blijkt dit echter verre van waar te zijn, want hoewel er zeker een deel van de aanwezige micro-organismen de extractie niet zullen overleven, blijven er altijd wel micro-organismen achter die de ‘aanslag’ wél hebben overleeft.

Verschillende micro-organismen die ziekteverwekkend kunnen zijn.
Micro-organismen en vervuiling zelfgemaakte zalf
Op internet verschijnen steeds meer zalven op basis van hennepextracten zoals zalf gemaakt van hennepwortel. Vaak worden er geen conserveringsmiddelen toegevoegd om het product zo natuurlijk en biologisch mogelijk te houden. Andere leveranciers beweren dat de ingrediënten in de zalf op zich al een anti-microbiële en anti-schimmel werking hebben waardoor het niet nodig zou zijn om het product te conserveren. In werkelijkheid blijkt dit helaas niet altijd voldoende te zijn.
Een crème of zalf is zonder conserveringsmiddelen een paradijs voor micro-organismen. Het functioneert namelijk als voedingsbodem voor deze kleine wezentjes. Vooral als deze rijk is aan vitamines, aminozuren en mineralen. Zalf op basis van water of op basis van een water in olie emulsie zijn extra gunstig voor de ontwikkeling van de micro-organismen. Elk organisme heeft namelijk water nodig om te kunnen leven.
Natuurlijke conserveringsmiddelen
Wanneer je dus een zalf maakt is het verstandig om voldoende ‘natuurlijke’ conserveringsstoffen toe te voegen, zoals bijvoorbeeld citroenzuur of natriumbicarbonaat (zuiveringszout). Micro-organismen kunnen namelijk moeilijk overleven in een zure of alkalische omgeving. Ook in producten met heel veel suiker kunnen ze vrijwel niet overleven, zoals bijvoorbeeld honing.
Vieze vingers
Verder moet er rekening worden gehouden met de gedragingen van de consument. Want wat gebeurt er na het openen van het product? En hoe moet de consument het product bewaren? Doordat de consument bijvoorbeeld voor het aanbrengen van de zalf met de vingers door het potje strijkt zullen er bacteriën van de vingers achterblijven in de zalf die zich aldaar zullen vermenigvuldigen tot enorme kolonies.
Als hetzelfde potje twee weken later wordt gebruikt voor het behandelen van bijvoorbeeld een schaafwondje of insectenbeet dan kan dit zeer ernstige infecties veroorzaken, want je smeert dan een kolossale hoeveelheid met potentiële pathogene ziekteverwekkers op de plaats die je juist wil behandelen om infecties te voorkomen.
Toxinen
Naast micro-organismen kunnen er ook toxinen aanwezig zijn in het plantmateriaal. Toxinen worden geproduceerd door schimmels en kunnen zeer schadelijk en zelfs kankerverwekkend zijn. Aflatoxine is een voorbeeld van een toxine die kan voorkomen en kanker kan veroorzaken. Als plantmateriaal toxinen bevat dan is het niet verstandig om er een extract van te maken omdat je de concentratie aan toxinen dan ook vergroot. Toxinen kunnen niet met behulp van sterilisatie onschadelijk worden gemaakt.
Temperatuur
Micro-organismen houden van warmte en zullen zich zeer snel vermenigvuldigen bij temperaturen boven de 15 graden. In een koele omgeving zijn de meeste micro-orgnanismen minder actief. De koelkast is dan ook een goed medium om bederfelijke producten in te bewaren. Er zijn zelfs bacteriën die in kokend water kunnen overleven. Temperatuur is dus een belangrijke factor voor de groei van micro-organismen.
Groeisnelheid
De snelheid van deze groei wordt uitgedrukt in het aantal delingen per uur. Een bacterie, die zich twee of drie maal per uur deelt, heeft een groeisnelheid van respectievelijk twee of drie. Vindt de deling eenmaal per 20 uren plaats, dan is de groeisnelheid 0,05. Bevindt een micro-organismen zich eenmaal in deze fase dan is de toename van de groei exponentieel.
Als Bedrocan de wiet niet zou bestralen dan is de kans groot dat je een potje vol met beschimmelde wiet opent waar je erg ziek van kunt worden
Dat wil zeggen dat er telkens in een vaste periode een verdubbeling plaatsvindt. Een cel deelt zich in twee cellen, twee delen zich in vier, vier in acht, acht in zestien, enz. In het begin lijkt deze toename nog niet zo spectaculair, maar na 10 delingen zijn er al 210, dat is meer dan duizend, en na 20 delingen zijn er 220, dat zijn er meer dan 100.000.
Exponentiële groei
Een Chinese legende verduidelijkt wat de exponentiële groei van micro-organismen betekent. De keizer van China was zo verrukt over het schaakspel, dat hij de uitvinder een beloning aanbood. De uitvinder mocht zelf kiezen wat hij wilde, behalve uiteraard het keizerrijk. De gewiekste uitvinder vroeg om één rijstkorrel op het eerste speelveld van het schaakbord, en twee op het tweede, vier op het derde, enzovoort, totdat het bord met 64 velden vol zou zijn.
‘Wat een bescheiden man!’ dacht de keizer aanvankelijk, en gaf opdracht wat rijst aan te laten rukken. Maar de uitvinder was de keizer te slim af. Als je de exponentiële trend doortrekt – zoals één korrel op het eerste veld, twee op het tweede, vier op het derde, enzovoort – is er voor het laatste veld van het schaakbord de gigantische oppervlakte van twee keer de aarde nodig.
In de onderstaande video zie je een voorbeeld van de exponentiële groei van de E. Coli bacterie:
Om een schone zalf te maken is het van groot belang dat de grondstoffen steriel zijn. Wortels simpelweg koken in heet water is niet voldoende om het te steriel te krijgen. Steriliseren kan in een huis-tuin-keuken omgeving alleen bij hogere temperaturen en onder hoge druk, bijvoorbeeld met een hogedrukpan of een UAE apparaat.
Extraheren en steriliseren
Als je een extract wilt maken die ook nog eens steriel moet zijn dan kan dit ook middels een vrij nieuwe techniek genaamd Ultrasonic Assisted Extraction (UAE). Een UAE apparaat is een soort ultrasone reiniger die op verschillende frequenties werkt en ook nog eens verhit kan worden.
Sterilisatie met ultrasone geluidsgolven werkt op basis van het Cavitatie-effect, veroorzaakt door ultrasone schokgolven van een hoge frequentie in een vloeistof zoals water of ethanol. Door de ultrasone golven worden er microscopische dampbelletjes gevormd en deze imploderen met grote kracht. Daardoor ontstaat cavitatie die een grote klap geeft aan de celwand van de micro-organismen, waardoor de celwand openbreekt en de meeste micro-organismen worden vernietigd. Hetzelfde effect heeft het openbreken van de celwand ook op de plantcellen waardoor de bestanddelen die zich in de cellen bevinden makkelijk kunnen oplossen in de extractievloeistof.
Bedrocan en gammabestraling
Bedrocan is overheidshalve verplicht om de wiet te bestralen met gamma-stralen om de groei van micro-organismen te remmen. Hoewel het bestralen mogelijk niet ten goede komt aan de kwaliteit van de wiet, zijn er weinig andere mogelijkheden om de groei van micro-organismen op grote schaal kostenefficiënt te remmen. Als Bedrocan de wiet niet zou bestralen dan is de kans groot dat je een potje vol met beschimmelde wiet opent waar je erg ziek van kunt worden.
Onthoud dat er een grote onzichtbare wereld bestaat met allemaal kleine wezentjes die onder bepaalde omstandigdheden ernstige gezondheidsproblemen kunnen veroorzaken
Voor patiënten met een slecht afweersysteem kunnen bepaalde micro-organismen zeer ernstige gevolgen hebben. Aangezien de doelgroep van de Bedrocan uit een kwetsbare groep mensen bestaat is het bestralen van wiet een betere optie dan het onbestraald verpakken van de wiet. Micro-organismen zitten overal en zo’n Bedrocan-potje zou zonder bestraling een broeikast voor pathogene ziekteverwekkers zijn.
HACCP
Maak je zelf CBD-olie of zalf en verstrek je deze aan derden? Dan is voor jou de HACCP van toepassing. HACCP staat voor Hazard Analysis and Critical Control Points. Bij het verwerken van voedingssupplementen zoals CBD-olie kunnen er dingen misgaan, wat de veiligheid van de consument in gevaar brengt. Iedereen die voedingssupplementen produceert of verwerkt voor de verkoop aan derden moet mogelijke risico’s beschrijven in een veiligheidsplan. Dit is een HACCP-plan. Alle leveranciers zijn wettelijk verplicht een HACCP-plan op te stellen. HACCP valt onder de Europese wetgeving.
Hazard: Een ‘hazard’ is een gevaar dat in een product aanwezig kan zijn en vervolgens een bedreiging voor de gezondheid van de consument kan vormen. Het gaat daarbij om:
- Microbiologische gevaren: bacteriën, schimmels, virussen en parasieten.
- Chemische gevaren, oftewel schadelijke stoffen: dioxines, zware metalen, schimmelgifstoffen, resten bestrijdingsmiddelen, enzovoorts.
- Fysische gevaren: glas, botdeeltjes, scherpe metaal- of houtdeeltjes, enzovoorts.
Naast een veiligheidsplan is ook persoonlijke hygiëne zoals het dragen van handschoenen, haarnetje en werkkleding belangrijk. Ook is een schone werkomgeving belangrijk. Het maken van voedingssupplementen hoeft niet per sé in een voedselverwerkingsbedrijf te gebeuren. Volgens de wetgever mag dit ook gewoon vanuit huis als er maar aan de HACCP wordt voldaan en de werkruimte HACCP-proof is.
Alles samengevat is het dus erg belangrijk om bij het maken van voedingssupplementen de hygiëne richtlijnen goed op te volgen. Want het ergste dat er kan gebeuren is dat mensen ziek worden van een product die juist is ontwikkeld om zieke mensen te helpen. Onthoud dat er een grote onzichtbare wereld bestaat met allemaal kleine wezentjes die onder bepaalde omstandigdheden ernstige gezondheidsproblemen kunnen veroorzaken.

Groetjes van Harry, het lieve onzichtbare beerdiertje : )
(advertentie)

























































